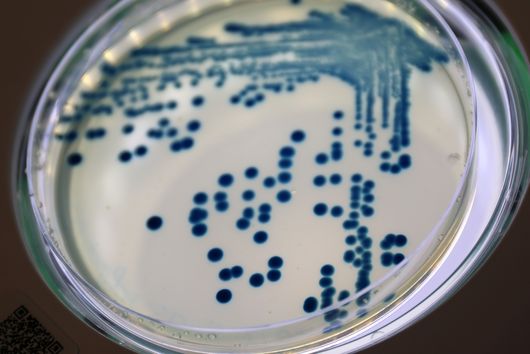

Das große Ganze im Blick
Die Gesundheit von Menschen, Tieren und Umwelt ist eng miteinander verknüpft und muss als ein großes Ganzes betrachtet werden. Am Helmholtz-Institut für One Health (HIOH) widmen wir uns der Erforschung dieses Gesamtbildes, indem wir die grundlegenden Mechanismen der Entstehung und Übertragung von Infektionskrankheiten sowie Antimikrobielle Resistenzen untersuchen. Damit tragen wir zur wirksameren Pandemievorsorge und -prävention bei.
Forschung am HIOH
Dem One-Health-Ansatz entsprechend befasst sich unsere Forschung mit der Bedrohung durch neu auftretende Krankheiten sowie mit der Evolution bekannter Krankheitserreger, einschließlich ihrer antimikrobiellen Resistenzen. Drei Hauptforschungsbereiche stehen im Mittelpunkt: Ökologie und Entstehung von Zoonosen, Evolution von Krankheitserregern sowie Epidemiologie und Ökologie von Antibiotikaresistenzen.
ONE HEALTH-KOHORTE
Anfang 2026 starten das HIOH und seine Kooperationspartner die erste One Health-Kohorte in Côte d‘Ivoire - eine zentrale Säule unserer One Health Exploratories
HIOH-Neubau nimmt Gestalt an
Neues Zuhause für unsere One Health-Forschung – hier geht’s zum aktuellen Blick auf die Baustelle

Webcam HIOH
Aktuelles aus dem HIOH
Neuigkeiten aus unserer Forschung und aktuelle Veranstaltungen am HIOH.
„Das One Health-Konzept ist der Schlüssel zu Pandemievorsorge und -prävention.”
Fabian Leendertz, Gründungsdirektor des Helmholtz-Instituts für One Health
Interessiert an einem spannenden Job am HIOH?
Hier geht’s zu unseren aktuellen Stellenausschreibungen.